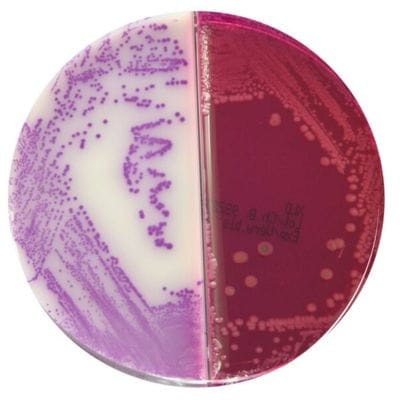
Brilliance_Salmonella_XLD_Agar_gotowa_pożywka_na_dzielonych_płytkach_Bestlabs.jpg

Brilliance Salmonella/X.L.D. Agar gotowa pożywka na dzielonych płytkach do wykrywania Salmonelli
• Opakowanie: 10 szt.
• Płytka dzielona: 90 mm.
• Do wykrywania Salmonelli.
• Wyrób medyczny: Tak.
 Opis
Opis
Brilliance Salmonella/X.L.D. Agar – gotowa pożywka na dzielonych płytkach do wykrywania Salmonelli
Brilliance Salmonella/X.L.D. Agar to wysokiej klasy podłoże mikrobiologiczne w formie dzielonych płytek, przeznaczone do selektywnej izolacji, różnicowania i wstępnej identyfikacji bakterii Salmonella spp. w próbkach żywności i środowiska. Dzięki zaawansowanej formule produkt gwarantuje wysoką czułość i selektywność, umożliwiając precyzyjne badania w laboratoriach diagnostycznych oraz badawczych.
Charakterystyka Brilliance Salmonella/X.L.D. Agar
Zaawansowane podłoże X.L.D. (ksyloza, lizyna, deoksycholan)
Podłoże X.L.D. Agar bazuje na mechanizmach fermentacji ksylozy, dekarboksylacji lizyny oraz produkcji siarkowodoru, które umożliwiają odróżnienie patogennych bakterii, takich jak Salmonella spp. i Shigella spp., od bakterii niepatogennych występujących w próbkach o mieszanej florze.
Brilliance Salmonella Agar – selektywność i łatwość odczytu
Część płytki zawierająca Brilliance Salmonella Agar oferuje wysoce selektywne środowisko z inhibitorami wzrostu bakterii takich jak Escherichia coli, co minimalizuje zakłócenia w badaniach. Dzięki specjalnym wskaźnikom barwnym kolonie Salmonelli są łatwe do zidentyfikowania wizualnie.
Specyfikacja produktu
Opakowanie i wymiary
- Ilość sztuk w opakowaniu: 10 sztuk.
- Średnica płytki: 90 mm (płytka dzielona na dwie sekcje).
Przeznaczenie
- Wykrywanie Salmonelli w próbkach żywności, środowiskowych oraz medycznych, zgodnie z normami ISO 6579.
Gotowa forma produktu
Płytki dostarczane w gotowej do użycia formie, co znacząco upraszcza proces badawczy i pozwala na szybkie uzyskanie wyników.
Zastosowanie Brilliance Salmonella/X.L.D. Agar
Diagnostyka laboratoryjna
Produkt jest szczególnie przydatny w laboratoriach mikrobiologicznych, które zajmują się badaniem próbek podejrzanych o obecność patogenów jelitowych, takich jak:
- Salmonella spp. – odpowiedzialna za zatrucia pokarmowe i salmonellozę.
- Shigella spp. – wywołująca czerwonkę bakteryjną.
Badania żywności i środowiska
Brilliance Salmonella/X.L.D. Agar jest zgodny z normami ISO 6579 i ISO 11133-2, co czyni go niezastąpionym w badaniach bezpieczeństwa żywności, monitorowaniu jakości środowiska oraz w analizach przesiewowych w sektorze produkcji spożywczej.
Zalety Brilliance Salmonella/X.L.D. Agar
Wysoka selektywność i czułość
Podłoże X.L.D. jest bardziej skuteczne w izolacji Salmonella spp. i Shigella spp. niż tradycyjne media, takie jak agary z błękitem metylenowym czy siarczynem bizmutu, które mogą hamować wzrost shigelli.
Dzielona płytka – podwójna efektywność
Płytki łączą dwa rodzaje podłoży: X.L.D. Agar oraz Brilliance Salmonella Agar, co pozwala na jednoczesne zastosowanie dwóch metod badawczych i oszczędność miejsca oraz czasu.
Optymalne warunki dla Salmonelli
Dodatek inhibitora wzrostu bakterii konkurencyjnych (np. Escherichia coli) oraz selektywne składniki zapewniają idealne warunki dla rozwoju i identyfikacji Salmonella spp..
Prostota i wygoda
Gotowe płytki eliminują konieczność przygotowywania podłoży w laboratorium, co skraca czas pracy i redukuje ryzyko błędów w przygotowaniu materiałów.
Instrukcja stosowania
- Otwórz opakowanie w warunkach aseptycznych.
- Na każdą sekcję płytki nanieś odpowiednią ilość próbki.
- Inkubuj płytki w zalecanych warunkach temperaturowych (35–37°C) przez określony czas (zazwyczaj 24–48 godzin).
- Odczytaj wyniki:
- Kolonie Salmonelli na X.L.D. Agar pojawiają się jako czerwone z czarnym środkiem (produkcja siarkowodoru).
- Kolonie Salmonelli na Brilliance Salmonella Agar mają charakterystyczne zabarwienie ułatwiające ich identyfikację.
Podsumowanie
Brilliance Salmonella/X.L.D. Agar to innowacyjne podłoże mikrobiologiczne łączące w sobie zalety dwóch różnych metod badawczych. Dzięki wysokiej selektywności i prostocie użytkowania jest niezastąpione w badaniach próbek żywności i środowiskowych. Gotowe do użycia płytki zapewniają szybkie i dokładne wyniki, spełniając wymagania nowoczesnych laboratoriów diagnostycznych.
___________________________________________________________________________________________________________________________________________________________________________________________
Jest to wyrób medyczny.
Wyrób medyczny przeznaczony wyłącznie do użytku profesjonalnego, zgodnie z definicją zawartą w art. 2 pkt 1.26 Ustawy o wyrobach medycznych. Produkty te nie są przeznaczone do stosowania w warunkach domowych. Zakupu mogą dokonać jedynie osoby posiadające Prawo Wykonywania Zawodu (PWZ) lub firmy, podając numer NIP podczas składania zamówienia. W przypadku zamówienia złożonego przez użytkownika domowego, zostanie ono anulowane, a ewentualna wpłata zwrócona na konto klienta.
__________________________________________________________________________________________________________________________________________________________________________________________
W powyższym linku znajdą Państwo bazę aktualnych certyfikatów firmy OXOID. Wystarczy wpisać numer LOT zamówionej przez Państwa partii, w celu uzyskania odpowiedniego certyfikatu.
 Koszty dostawy
Cena netto, nie zawiera podatku
Koszty dostawy
Cena netto, nie zawiera podatku
darmowa i wygodna wysyłka
już od 800 zł netto
Najwyższa jakość
produktów potwierdzona certyfikatami
Zakupy 24h na dobę
wygodne i bezpieczne
bezpłatna konsultacja
z ekspertem online